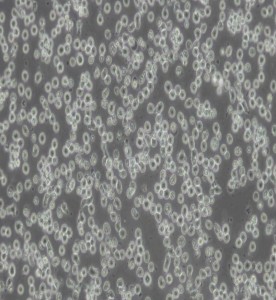
MOLT-4人急性淋巴母細胞白血病細胞主圖

酶聯(lián)承諾
-
品質保證
防偽易碎商標貼,四招助您分辨真假。 -
送貨保障
產品均有現(xiàn)貨,多家快遞公司合作準時到達。 -
售后服務
產品及實驗問題,提供技術支持保障。
酶聯(lián)試劑服務
幫助與支持
關注酶聯(lián)


上海酶聯(lián)生物科技有限公司
Shanghai Enzyme-linked Biotechnology Co., Ltd.
訂購熱線:15921990938 / 021-54720761
傳 真:021-54222852
地址:上海市松江區(qū)云凱路66號T2樓1603室
 酶聯(lián)官方手機二維碼
酶聯(lián)官方手機二維碼
微信掃描二維碼,參與酶聯(lián)活動, 勁爆優(yōu)惠觸手可得!